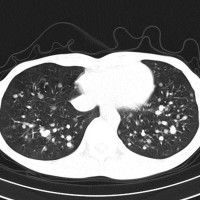
glomusuiy2

傍神経節腫 パラガングリオーマ,グロームス腫瘍
いろいろな名前で呼ばれます
グロームス腫瘍、グロムス腫瘍 glomus tumor
傍神経節腫 パラガングリオーマ paraganglioma
化学受容体腫瘍 ケモデクトーマ chemodectoma
神経内分泌腫瘍 neuroendocrine tumor
いろいろあってめんどくさいのですが,WHOの病理分類では paragangliomaとされていますので,正確にはカタカナで「パラガングリオーマ」と呼ぶのが適切です。大分類としての神経外胚葉腫瘍のなかの,神経内分泌腫瘍のなかの,パラガングリオーマ 傍神経節腫です。副腎にできる褐色細胞腫 pheochromocytomaは同じものです。脳神経外科では頭蓋底に多く,「グロームス腫瘍」と呼ばれることが多いでしょう。
おおまかなこと
- WHO グレード1の良性の腫瘍です
- 自律神経節 segmental automomic ganglia / paraganglia から発生します
- 中枢神経系では,脊柱管内馬尾にできる spinal paragangliomaの頻度がもっとも高いです
- 頭蓋底(頭の底部の骨の中)にできることも多いので,場所としては頭蓋底腫瘍に分類されます
- 40代の成人にもっとも多くみられます
- 大した症状がないものは治療しないでほっておきます
- 見つかっても勢い込んで手術をしない
- 何年も経過観察してもほとんど大きくならない巨大なグロームス腫瘍もあります
- 最も多いのが鼓室にできるもので,脈打つような耳鳴り(拍動性耳鳴),聴力低下,耳の穴から出血する(外耳道出血)などで発症します
- 耳鼻科で耳の穴からのぞくと,赤いので血管腫だと診断されます
- 頭蓋底のものでは,せき(理由のない咳発作),しゃがれ声(嗄声),飲み込みづらい(嚥下障害),顔面がゆがむ(末梢性顔面神経麻痺)などの症状です
- 頚動脈にできるものは,首の横がふくれてくるので気づかれます
- カテコラミンを分泌する腫瘍では,ひどい高血圧と動悸がでます
- 血管に富む腫瘍 hypervascular tumor で,たくさんの動脈が流入して火の玉みたいな血管腫に見えます
- まれに肺転移を生じます
脳腫瘍、頭蓋底腫瘍としてのグロームス腫瘍の発生部位
- 鼓室 tympanum : glomus tympanicum (tympanum) tumor
- 頸静脈球 jugular bulb : glomus jugulare tumor
- 迷走神経節 vagal ganglion : glomus vagale tumor
- 頸動脈小体 carotid body : carotid body paraganglioma, glomus caroticum tumor
機能性パラガングリオーマ
- パラガングリオーマはもともと,自律神経節 autonomic gangliaから発生する腫瘍です
- 神経内分泌腫瘍と言われます
- ですから,自律神経節細胞の働きをすることがあります
- カテコラミン catecholamineを分泌するものを機能性パラガングリオーマ functional paragangliomaといいますが,数%くらいでめずらしいものです
- 症状は,難治性高血圧,動悸,頭痛と発汗など
- もともとかなりの高血圧ですから,これを認識しないと,手術中に腫瘍を摘出した瞬間に低血圧に見舞われます
- 手術で腫瘍をいじるときは降圧剤,腫瘍を摘出した後は昇圧剤を使います
- 手術後に降圧剤を中止しないと低血圧症状を出します
- 術後管理では低血圧による脳梗塞や心筋梗塞の発症にも気をつけます
検査
- MRIでほとんど確定診断できます,拡散強調画像 DWIで高信号になるのも特徴です
- CTで側頭骨の破壊の程度をみます
- 手術するということが決まった時だけ,カテーテルによる血管撮影 DSA をします
治療(手術摘出)
- まず,手術しなければならないかどうかを慎重に考えます
- 鼓室の中にできたものは耳鼻科で手術します
- 頚動脈の分岐部(頸動脈小体)にできたものは,内頚動脈との剥離さえ慎重にすれば全摘出しても手術後遺症を残さないでできます
- 頸静脈球に発生したものは,かなり大きなものしか手術適応になりません
- ですから,それを摘出すると嚥下障害や嗄声や副神経麻痺(頸肩部の筋肉が萎縮する)などの手術合併症の頻度がとても高いと言えます
- 大掛かりな頭蓋底手術をしないことが大切です
- ものすごく出血するので,最初に腫瘍に流入する動脈を止めますが,それさえしっかりできれば後は慎重に剥離するだけです
- 手術がもっとも困難なタイプは,FIsch class D (Ugo FIschという有名な耳鼻科医の分類)のグロームス腫瘍で,頭蓋内伸展があるものです
- クラスDでは,頚静脈孔から小脳延髄角部に腫瘍が伸びて,延髄を圧迫して,椎骨動脈系から腫瘍動脈を引き込みます
- この手術だけはとても難易度が高くて難しいでしょう
ちょっと難しいグロームス腫瘍
耳の聞こえと飲み込みが悪くなって発症(難聴と嚥下障害)した20代の患者さんのグロームス腫瘍 jugular paragangliomaです。左の頚動脈撮影 CAGでは,頸部の腫瘍におされて内頚動脈が前方に屈曲しています。外頚動脈から多くの血管が流入して血管腫のように濃い腫瘍陰影がみえます。右側の椎骨動脈撮影 VAGでは,頚静脈孔から頭蓋内の小脳延髄角部まで伸びた腫瘍が染まります。頭蓋内はPICAから頸静脈球と頸部には椎骨動脈の筋肉枝からの腫瘍血管がみられます。


頸部から頸静脈球を抜けてS上静脈洞内に入ります。これはクラスCかDか迷うところです。ちょっと難しい。またこのサイズでは,迷走神経と舌咽神経の機能を温存することができません。延髄方向へ伸展していますし年齢が若いので手術せざるを得ないものでした。


この腫瘍は放射線治療で制御できるものではないでしょう。手術で全摘出できて10年以上再発はありません。嚥下障害と強い嗄声が残りましたが,働いて社会生活はできています。
治療(放射線治療)
- 手術摘出できるものは手術が第一選択です
- でも頭蓋底に限局するものなどは放射線治療の適応となります
- 放射線治療は有効ですから,手術治療との適否をよくよく考えます
巨大なものでもほっといていい
治療しなくてもいいものも多い腫瘍です


左は1991年,右は2006年のMRI画像です。15年間で腫瘍のサイズは変わっていません。
1991年に50代の女性にみつかったものでした。黄色に示したルートで摘出できないわけではありませんが,右後頭部が腫れてきたという訴えとホルネル症候,軟口蓋麻痺しかなかったので,何も治療しないでほっておきました。2016年まで25年間観察し続けました。症状の悪化は全くなく元気に暮らしておられます。グロームス腫瘍はある一定の年齢になると増大しないという性質を持っている良性腫瘍です。これを大々的な頭蓋底外科手術で摘出するするという愚を犯してはなりません。
悪性のパラガングリオーマ?
- 基本的には悪性腫瘍にはなりません,グレード1のままです
- でもきわめてまれに,頸静脈を介して肺転移します
- 髄膜腫の肺転移と同じような,ゆっくりとした進行という予後となります
- これは頸静脈を介してのこぼれ落ちるような肺転移です
- ですから,頸静脈を遮断するような腫瘍摘出手術をすれば予防できるという考え方もあります
多発性肺転移が発見され無治療で14年が経過しました。肺転移巣は無数ですがたいして増大しませんので普通の生活ができています。
先天性(家族性)パラガングリオーマ
- 常染色体優性遺伝します
- 神経節腫と褐色細胞腫が多発します
- 30代で発見されることが多く,100万人に1人くらいの発生率です
- 原因遺伝子は,SDHD gene (type 1), SDHAF2 gene (type 2), SDHC gene (type 3), SDHB gene (type 4)です。type 4だけで悪性腫瘍が発生します。



遺伝歴があり30代くらいです。黄色の矢印で示す右側はglomus vagale,左側は上がglomus jugulare、左下がglomus caroticumです。教科書に載せたいくらい典型的な部位に発生しています。無症状ですからもちろん治療はしません。6年くらい経過観察していますがほとんど増大もしません。
神経内分泌腫瘍としての機能性パラガングリオーマの治療
Kong G, et al.: Efficacy of Peptide Receptor Radionuclide Therapy for Functional Metastatic Paraganglioma and Pheochromocytoma. J Clin Endocrinol Met, 2017
切除困難な高血圧を生じる機能性パラガングリオーマに,ペプチド受容体放射性核種治療 peptide receptor radionuclide therapy (PRRT)が有効であるとの報告です。米国では商品化され,2018年1月にFDAはルタセラを承認しましたが,日本では未承認です。
他に消化器では,ソマトスタチンアナログ,エベロリムス,スニチニブ,ストレプトゾシン,PRRTなどが用いられますが,頭頸部の機能性パラガングリオーマに関する報告は希薄です。
病理
巣状,分葉状構造を示す Zellballen pattern という特徴的な組織像を示します。WebでZellballen pattern figure を検索すると画像がたくさん出ます。
キャッスルマン病:パラガングリオーマと術前診断を間違えたもの
10歳くらいから頸部に腫瘍があり生検術をされましたが診断がつかず,31歳までなにも治療をしなかった患者さんです。20年間でかなりゆっくり大きくなりました。
 30代で,血行性肺転移が多発しているという診断を受けました。20年以上の病歴があり,多くの血管に富むhypervascular tumorであったために,良性腫瘍であるパラガングリオーマの肺転移という術前診断で頸部腫瘍の摘出をしました。
30代で,血行性肺転移が多発しているという診断を受けました。20年以上の病歴があり,多くの血管に富むhypervascular tumorであったために,良性腫瘍であるパラガングリオーマの肺転移という術前診断で頸部腫瘍の摘出をしました。
全摘出して術後経過に問題はありませんでしたが,病理診断は,全体がリンパ球と胚中心様の構造でCastleman diseaseでした。発熱や倦怠感などの症状がなく軽症の単中心性キャッスルマン病として経過したものかもしれません。
文献
放射線治療で制御できるものが多い
Treatment of head and neck paragangliomas with external beam radiation therapy. Int J Radiat Oncol Biol Phys 2014
1990年から2009年の間に66人の患者さんが,放射線治療(中央値45グレイ)を受けました。中央値30mlですから比較的小さいものが多いです。側頭骨51例,頚動脈球18例,迷走神経起源10例です。追跡期間中央値は4.1年でした。1例の患者さんだけで照射後8年で再燃がありました。5年腫瘍制御割合は98.7%という高率でした。